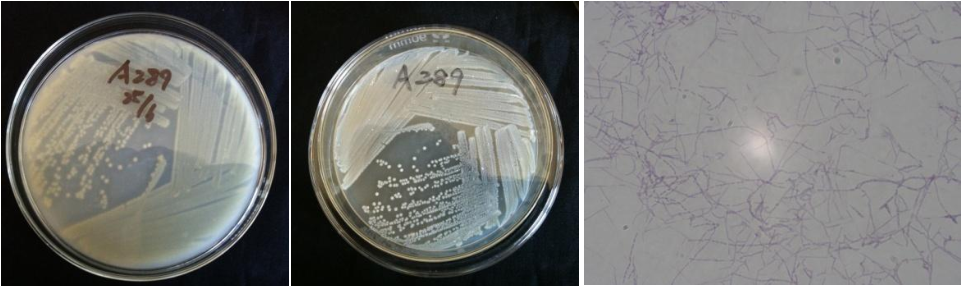

Loading...
| StrainNO | A289 |
| Classification | Amycolatopsis |
| 16s rDNA sequence | |
| Strain Morphology Photos | |
| Morphological Description | Mycelia branch;separation is not broken;fine mycelia;straight spore silk;and mycelia all broken into Rod or barrel spore pile squid gray;light mango brown back |